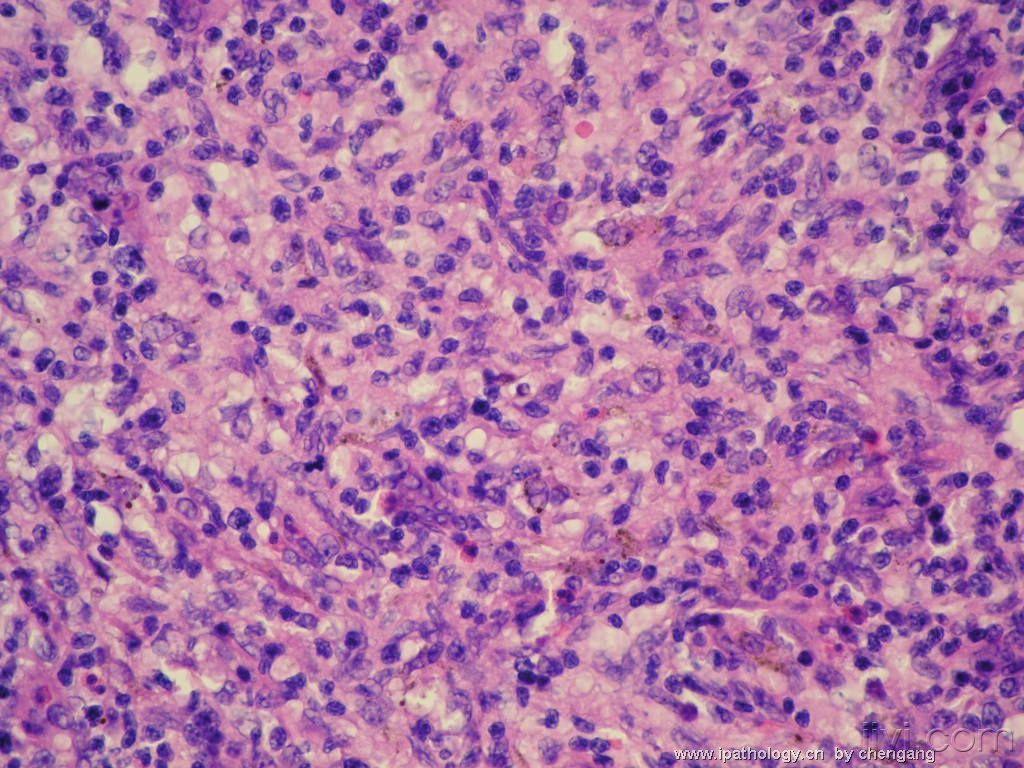
20:43:35淋巴结部分淋巴滤泡保留,滤泡间区和副皮质区增宽,呈结节状和

淋巴结皮质图片

一波淋巴结的美图来袭|皮质|浆细胞|淋巴细胞_网易订阅
图片尺寸660x374
淋巴结皮质
图片尺寸340x380
100个切片,注明理由, 被摸 小结帽 明区 淋巴小 结 暗区 副皮质区
图片尺寸1080x810
脖子上出现"小肉疙瘩",可能是癌细胞复活的前兆,早发现早治疗_淋巴结
图片尺寸640x438
一波淋巴结的美图来袭|皮质|浆细胞|淋巴细胞_网易订阅
图片尺寸633x373
正常淋巴结结构如图所示对皮质区描述不正确的是
图片尺寸572x431
淋巴结皮质模式图
图片尺寸390x400
淋巴结切片 图1可见被膜 淋巴小结 弥散淋巴组织 副皮质区 图2可见
图片尺寸1322x1280
20:43:35淋巴结部分淋巴滤泡保留,滤泡间区和副皮质区增宽,呈结节状和
图片尺寸1024x768
组胚绘图-淋巴结 p5 皮质 p6-8 髓质
图片尺寸1280x1280
淋巴结具有哪些结构?它在人体免疫中发挥着什么重要作用?
图片尺寸800x558
淋巴结皮质
图片尺寸1920x1082
淋巴结节图
图片尺寸4096x2731
图像名称猕猴恒河猴淋巴结浅层皮质颈部淋巴结he染色
图片尺寸499x400
淋巴结皮质
图片尺寸1920x2560
示教法
图片尺寸530x428
组胚切片 #淋巴结 #胃 #小肠
图片尺寸1080x1439
组胚绘图-淋巴结 p5 皮质 p6-8 髓质
图片尺寸1319x1319
因此,脖子上的淋巴结也是最容易肿大的部位.
图片尺寸640x480
20:43:35淋巴结部分淋巴滤泡保留,滤泡间区和副皮质区增宽,呈结节状和
图片尺寸1024x768